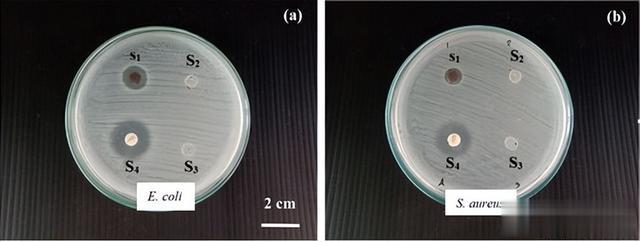

前言
前言纳米复合材料是一种包含各种功能性纳米材料的新型材料,因其改善物理和化学性质的特点而受到科学界的广泛关注。
近来,人们对以纤维素为基础的复合支架,与其他成分混合制备的兴趣逐渐增长,特别是将金属纳米颗粒用于抗菌应用。

纤维素可以由细菌产生,这种类型的纤维素被称为细菌纤维素(BC)。BC天然存在于非常纯净的纳米级纤维中,使用前无需额外的纯化处理。由于BC具有高结晶性和刚度等特点,近来在工业应用中引起了广泛关注。

其中一种应用就是将BC与银纳米颗粒(AgNPs)结合使用。AgNPs因其局部表面等离激元共振(LSPR)等光学性质而备受关注。
我们将AgNPs与BC进行混合,通过一种绿色、经济实惠且简单的方法,将BC浸渍在含有AgNPs的水溶液中,从而形成了BC-AgNPs复合材料。
 材料和方法
材料和方法1.银NPs的合成
为合成AgNPs,取5克干燥的Moringa oleifera Lam.叶片细切碎,并用100毫升蒸馏水提取,制备叶提取物溶液(MLE),用于将Ag离子(Ag)还原为Ag NPs(Ag+0)。
随后,取1.50毫升MLE与固定浓度的50毫升AgNO3,在60摄氏度的水浴中反应50分钟。在温度处理过程中,通过观察反应溶液的颜色变化来观察AgNPs的还原过程。

记录它们的紫外-可见光谱,以研究AgNPs的形成过程。反应完成后,通过离心法在10000转/分钟的速度下离心15分钟,收集胶体溶液,然后用蒸馏水洗涤两次以去除未反应的物质和杂质。
最后,收集的粉末进行干燥、表征和储存,以备进一步使用。

2.细菌纤维素生产
细菌纤维素由G. xylinus BKNC 19产生,培养在农业废弃物培养基中(83.24毫升/升香蕉提取物,5克/升酵母提取物,5克/升肽酶)。
使用高效液相色谱法(HPLC)分析香蕉提取物的糖含量。将培养基中的总糖含量调整为与标准培养基(Hestrin和Schramm培养基)中葡萄糖水平相匹配,并在30摄氏度下静态条件下培养7天。

培养后,BC菌膜在培养基表面形成,并被收集后用0.5N NaOH溶液煮沸10分钟,然后冲洗直至pH中性。将菌膜存放在蒸馏水中以备进一步使用。
3.表征
我们使用一种称为紫外-可见(UV-Vis)分光光度计的仪器,对合成的AgNPs的光吸收性质进行了研究。
并在波长范围从300到750纳米进行了测量,可以准确分辨出1纳米的差异。此外,通过透射电子显微镜(TEM),我们还观察和确定了这些纳米颗粒的形状、大小和结构。

为了了解其晶体性质,研究者们运用了TEM高分辨率模式下的选区电子衍射(SAED)技术。
另外,为了分析AgNPs、BC和BC-AgNPs复合材料的结构和结晶性,研究者们使用了X射线衍射(XRD)仪器,其中的X射线能量来自Cu(Kα)辐射源。XRD谱图在2θ角度范围内从10到80°进行记录,每次步长为0.2。

他们还使用一种名为Shimadzu FTIR光谱仪的设备,在衰减全反射模式下分析了MLE、AgNPs、BC和BC-AgNPs复合材料的傅里叶变换红外光谱(FTIR)谱图。
这种技术能够提供样品中有机功能性团的信息。他们在波数范围为4000到500 cm^-1之间进行了测量,并以4 cm^-1的分辨率记录数据。

4.BC-AgNP纳米复合材料的抗菌性能
为了研究BC-AgNPs纳米复合材料的抗菌能力,我们选择了两种不同的致病微生物进行测试。这两种模型细菌分别是引起感染的革兰氏阴性菌E. coli和S. aureus。
测试使用了一种称为圆盘扩散实验的方法,在含有营养琼脂(NA)的琼脂平板上进行。首先,新鲜的细菌培养物被传到NA平板上,并轻轻地均匀涂抹在表面上。

然后,从BC-AgNPs纳米复合材料中切割出样品纤维,并在紫外辐射下进行2小时的灭菌处理。这些处理过的圆盘被放置在细菌散播的NA平板表面上。
为了让BC-AgNPs纳米复合材料更好地扩散到细菌细胞表面,NA平板被孵育在37°C的恒温条件下。
在孵育了18小时后,观察到圆盘周围的抑菌区域,并用游标卡尺测量它们的宽度。通过这种方法,我们能够评估BC-AgNPs纳米复合材料,对这两种致病微生物的抑制效果。
 结果和讨论
结果和讨论1.AgNPs的合成和性质
在与AgNO3反应后,MLE呈现出黄棕色,这被视为AgNPs形成的初步迹象(。UV-Visible光谱进一步确认了胶体AgNPs的形成,如下图所示。

在约440nm处观察到吸收峰,表明AgNPs中导电电子的集体振荡,即所谓的LSPR。下图中的TEM图像显示,合成的AgNPs几乎是球形的,与UV-Visible光谱数据一致。粒径分布直方图(图d)显示AgNPs的直径在5到35纳米范围内。

SAED图案中的明亮圆形斑点(图c)表明形成的AgNPs具有晶体结构。使用FTIR研究了MLE中存在的植物化学成分及其在合成和稳定AgNPs过程中的作用。

MLE的FTIR谱显示出各种振动带,包括强度为3328 cm−1的羟基(–OH)基团的伸缩振动。
2883 cm−1和2974 cm−1处的带子与脂肪族C–H伸缩振动相关,而1656 cm−1和1452 cm−1处的带子对应于羧基的不对称和对称伸缩振动。
其他带子在1379 cm−1处(CH3的对称弯曲)、1326 cm−1处(C–H弯曲)、1274 cm−1处(–SO3的伸缩振动)和1045 cm−1处(来自醇、羧酸、酯、醚以及胺的C-O伸缩振动)。

与AgNO3反应后,MLE的FTIR谱中的特征峰移动、消失或保持不变。3328 cm−1到3318 cm−1和1656 cm−1到1636 cm−1的峰值移动,以及与AgNO3反应后2883 cm−1和2974 cm−1处的峰值消失,表明槐树叶的生物分子可能对AgNPs的还原和稳定负责。
XRD分析合成的AgNPs显示出四个特征衍射峰,在2θ值分别为38.2°、44.5°、64.6°和77.7°处,对应于Ag的面心立方结构的(111)、(200)、(220)和(311)晶面。

在2θ=27.9°、32.4°、46.4°和55.5°处观察到的附加峰归因于槐树叶中存在的有机基团,这些基团在还原Ag离子和形成AgNPs的过程中起作用。
为了建立数据库,将获得的AgNPs的合成和性质与使用其他天然产物提取物合成的AgNPs进行了比较,如下表所示。

2.BC的生产和属性
下图显示了由G. xylinus BKNC 19利用农业废弃物,即香蕉汁,并加入氮源作为培养基所产生的BC。在经过NaOH处理前和处理后,BC凝胶的颜色分别为黄色和白色(见下图a和b)。

BC的黄色可能是由于培养基的颜色。所有BC样品的菌膜经过NaOH处理以去除G. xylinus和相关生物质,从而得到纯化的白色菌膜(见图b)。

下图显示了使用FE-SEM在放大倍数为×10k(图a)、×30k(图b)和×50k(图c和d)的条件下,分析的冷冻干燥BC样品的表面形态。FE-SEM图像显示,丝带状微纤维的三维网络形成了高度纤维状的结构。

大多数微纤维宽度约为40-70纳米,并交织在纳米尺寸的结构中。由于其末端在低放大倍率(×10k)下不可见,因此无法确定微纤维的长度。XRD谱图显示了从2θ=10∘到80∘的冷冻干燥BC的衍射峰。

已报道BC的(11¯0)、(110)和(200)晶面,在本文中在2θ=14.86∘、17.70∘和23.63∘处可以观察到。这些衍射峰是纤维素的特征。
此外,从图a中可以清楚地看出,BC不是完全结晶的材料,其BC膜的衍射图样显示出宽峰。

冷冻干燥BC的FTIR谱显示了BC的特征峰,例如强度为3345厘米−1的强带(O-H键的伸缩振动)、1428厘米−1和不对称角变形的C-H键)、1135厘米−1(对称角变形的C-H键)、1161厘米−1(C-O-C缔合键的不对称伸缩振动)、1056厘米−1和1109厘米−1(次要和主要醇中C-OH和C-C-OH键的伸缩振动)以及897厘米−1对应于C-H键的角变形。

3.抗菌活性评估
我们使用圆盘扩散方法评估了BC-AgNP纳米复合材料的抗菌活性,并测试了革兰氏阴性菌E. coli和革兰氏阳性菌S. aureus作为测试对象。
实验结果显示,BC-AgNP纳米复合材料呈现出明显的抑菌区域,表明其抗菌性能良好。对S. aureus和E. coli的最大抑菌区域分别为9.50 ± 0.50和13.17 ± 0.58毫米。
这一结果通过图9中S1样品的照片清晰可见,BC-AgNP纳米复合材料对E. coli和S. aureus细菌显示出显著的抑菌效果。
抑制E. coli的效果比抑制S. aureus的效果更为明显。这可能是由于两种细菌的特性不同,包括细菌细胞壁和膜结构的厚度和成分差异所导致的。

此外,本研究中的BC基质和BC与MLE复合材料在所使用的浓度下,未显示出抑菌区域。这表明BC-AgNP纳米复合材料具有显著的抗菌效果。
2.BC-AgNPs纳米复合材料的长期抗菌性能
为了研究BC-AgNPs复合材料,对革兰氏阳性菌S. aureus和革兰氏阴性菌E. coli,在培养基中长时间48小时内的抗菌效果,我们通过测量在600纳米波长处的光密度(OD600)来调查细菌的生长情况。

如下图所示,分别以不含BC-AgNPs复合材料的培养基中的E. coli(图a)和S. aureus(图b)的生长曲线作为对照组,显示在前24小时内迅速生长。
而在含有250 µg/ml浓度的BC-AgNPs复合材料的培养基中,E. coli和S. aureus的生长仅在最初的16小时内被观察到,之后两种细菌略有开始生长。

这是因为该浓度等于两种细菌的最小抑菌浓度(MIC),只抑制了细菌的生长。研究表明,在含有与MIC相等浓度的AgNPs的培养基中,经过10小时的孵育,E. coli和S. aureus的细菌生长观察到OD600值增加。
而含有500 µg/ml和2000 µg/ml浓度的BC-AgNPs复合材料,分别等于E. coli和S. aureus的最小杀菌浓度(MBC),在48小时的时间内完全抑制了两种细菌的生长。

然而,影响AgNPs抗菌活性的因素有很多,包括颗粒大小、形状、稳定剂及其剂量以及处理时间。
AgNPs对细菌活性的抑制作用机制是,当元素银纳米颗粒与细菌细胞壁接触时,银离子从纳米颗粒表面释放出来。
由于金属纳米颗粒的纳米结构大小,改变了表面的局部电子结构(电子效应),可能增强了纳米颗粒表面的反应性。

随后,银离子可能破坏或渗透细胞膜,导致酶活性的严重降低,从而改变微生物的代谢并抑制它们的生长,导致细胞死亡。
此外,AgNP是软酸,具有与碱反应的天然趋势。因此,它倾向于与软碱发生更强的亲和反应。细菌的细胞膜主要由磷酸、含硫蛋白质以及DNA等含磷化合物组成,这些都是软碱。

AgNPs对细胞的作用可以引发反应,随后导致细胞死亡。最后,AgNP释放出银离子,这对AgNP的杀菌效果有额外的贡献。
此外,AgNPs对E. coli的抗菌活性比对S. aureus更强。这可以归因于它们对AgNPs的敏感性差异,即细菌细胞膜的厚度和成分不同。
 结论
结论我们使用XRD、FTIR、TEM、FESEM和SAXS分析来研究这种复合材料的生产过程。
通过FE-SEM形态学观察,可以看到AgNPs以独立的球形颗粒,或聚集体的形式均匀地分布在BC基质中。XRD的结果确认了BC-AgNP纳米复合材料中存在AgNPs。

SAXS的表征结果显示,嵌入在BC中的AgNPs尺寸约为19纳米,这与TEM结果相一致。BC-AgNP纳米复合膜对S. aureus和E. coli细菌表现出很好的抗菌活性。
然而,BC-AgNP纳米复合材料对E. coli的生长抑制效果要比对S. aureus菌更强。这些结果表明,BC-AgNP纳米复合材料可以考虑用于包装和生物医学应用。
 参考文献
参考文献Dubey P, Bhushan B, Sachdev A, et al. 银纳米颗粒掺入复合纳米纤维,用于潜在的伤口敷料应用。应用理工科学杂志 2015;132:42473.
Gopiraman M, Jatoi AW, Hiromichi S, et al. 银涂层阴离子纤维素纳米纤维复合材料具有有效的抗菌活性。碳水化合物聚合物。2016;149:51–59.
Ito H, Sakata M, Hongo C, et al. 具有取向银纳米颗粒的纤维素纳米纤维纳米复合材料.纳米复合材料。2018;4(4):167–177.
张鑫, 施鑫, 高特罗特, 等. 纳米工程静电纺丝纤维及其生物医学应用研究进展.纳米复合材料。2021;7(1):1–34.
Soemphol W, Charee P, Audtarat S, et al. 由农业废弃物制备的细菌纤维素-二氧化硅纳米复合材料的表征.母校快车。2020;7(1):015085.
